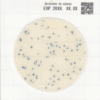
EASY PLATE SA 24hr Staphylococcus aureus - 1000plates

EASY PLATE SA 24hr Staphylococcus aureus
Price range: £153.29 through £1,221.77 ex. VAT
Easy Plate SA is an AOAC PTM certified custom media formulation for cultivation of Staphylococcus aureus. A microbial test kit that contains a chromogenic substrate that produces easily distinguishable brightly colored blue colonies, allowing you to easily identify and quantify Staphylococcus aureus. Compared to Baired-Parker agar and Mannitol salt agar with egg yolk which takes 48 hrs, Easy Plate SA incubation time is reduced to in 24±1 hrs. Easy Plate SA also contain inhibitors reducing the growth of non- Staphylococcus aureus, but if they grow, the colonies will exhibit a pink to red-violet color making them easy to distinguish. Easy Plate SA is AOAC PTM certified and sold in packages of 100 tests in 4 separate bags containing 25 tests each. The shelf life of 12 months when stored unopened at 2-8℃.
| Pack-size | 100plates, 1000plates |
|---|